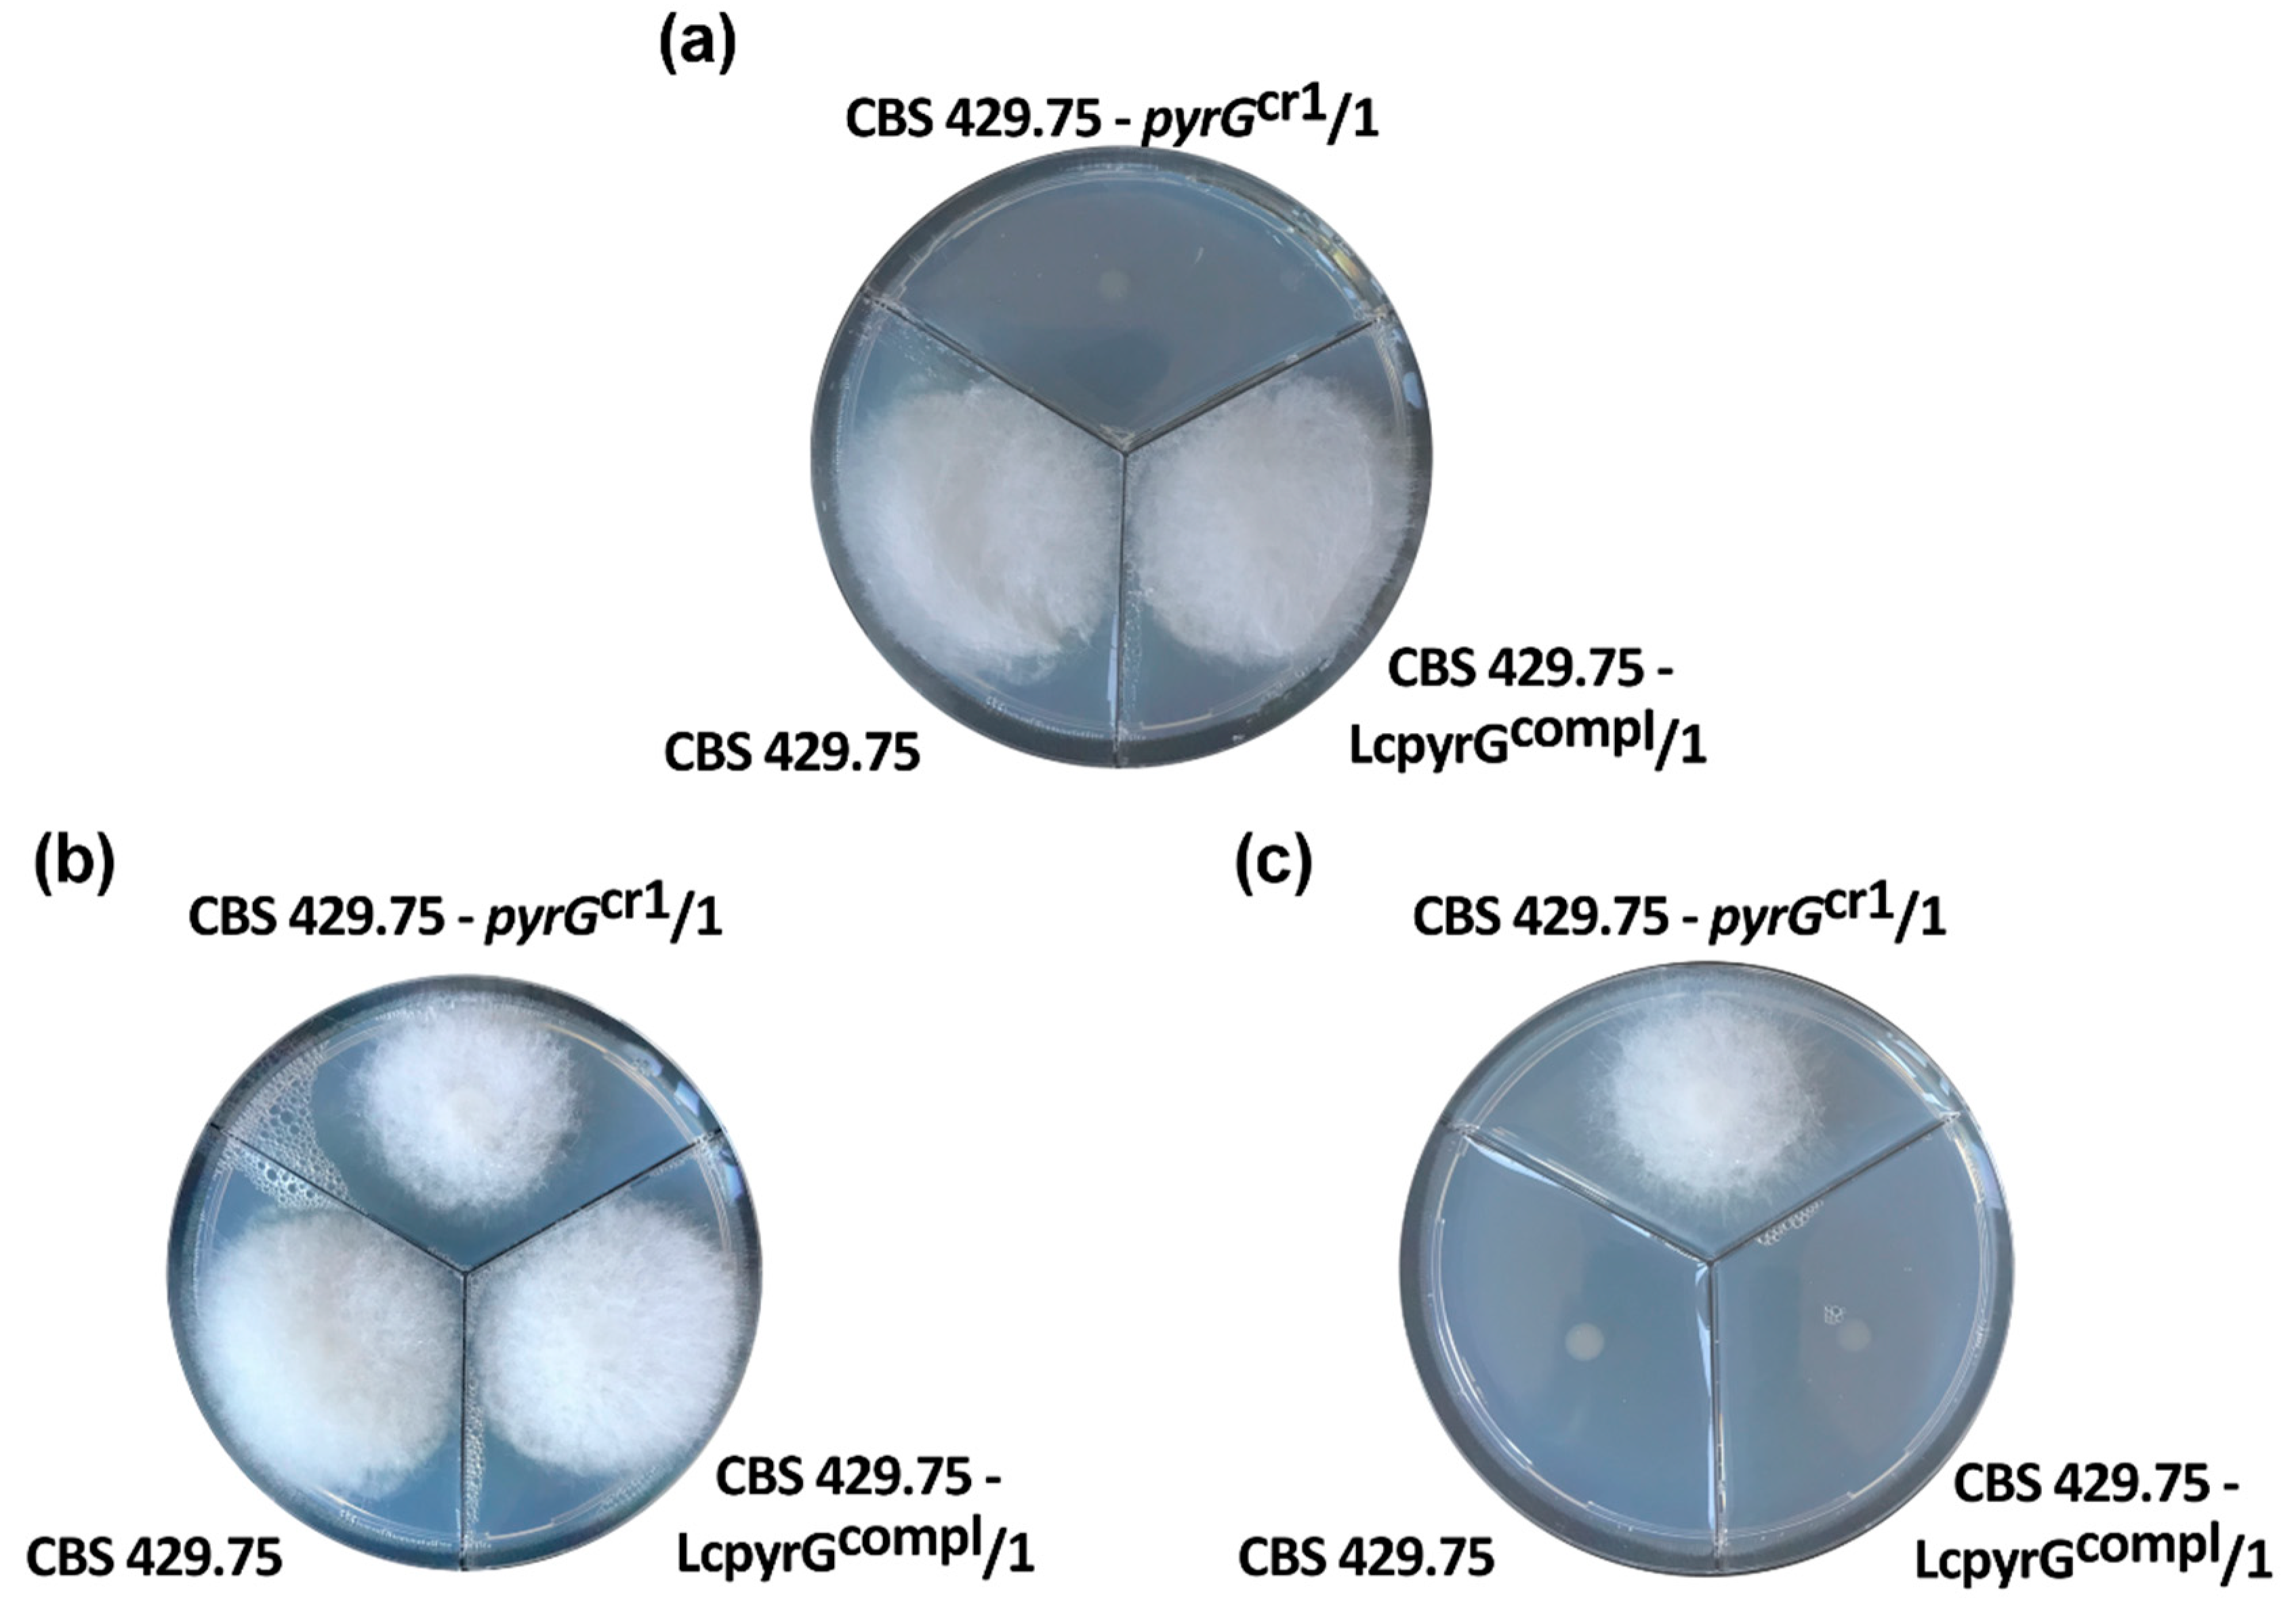
Ijms 21 03727 g001
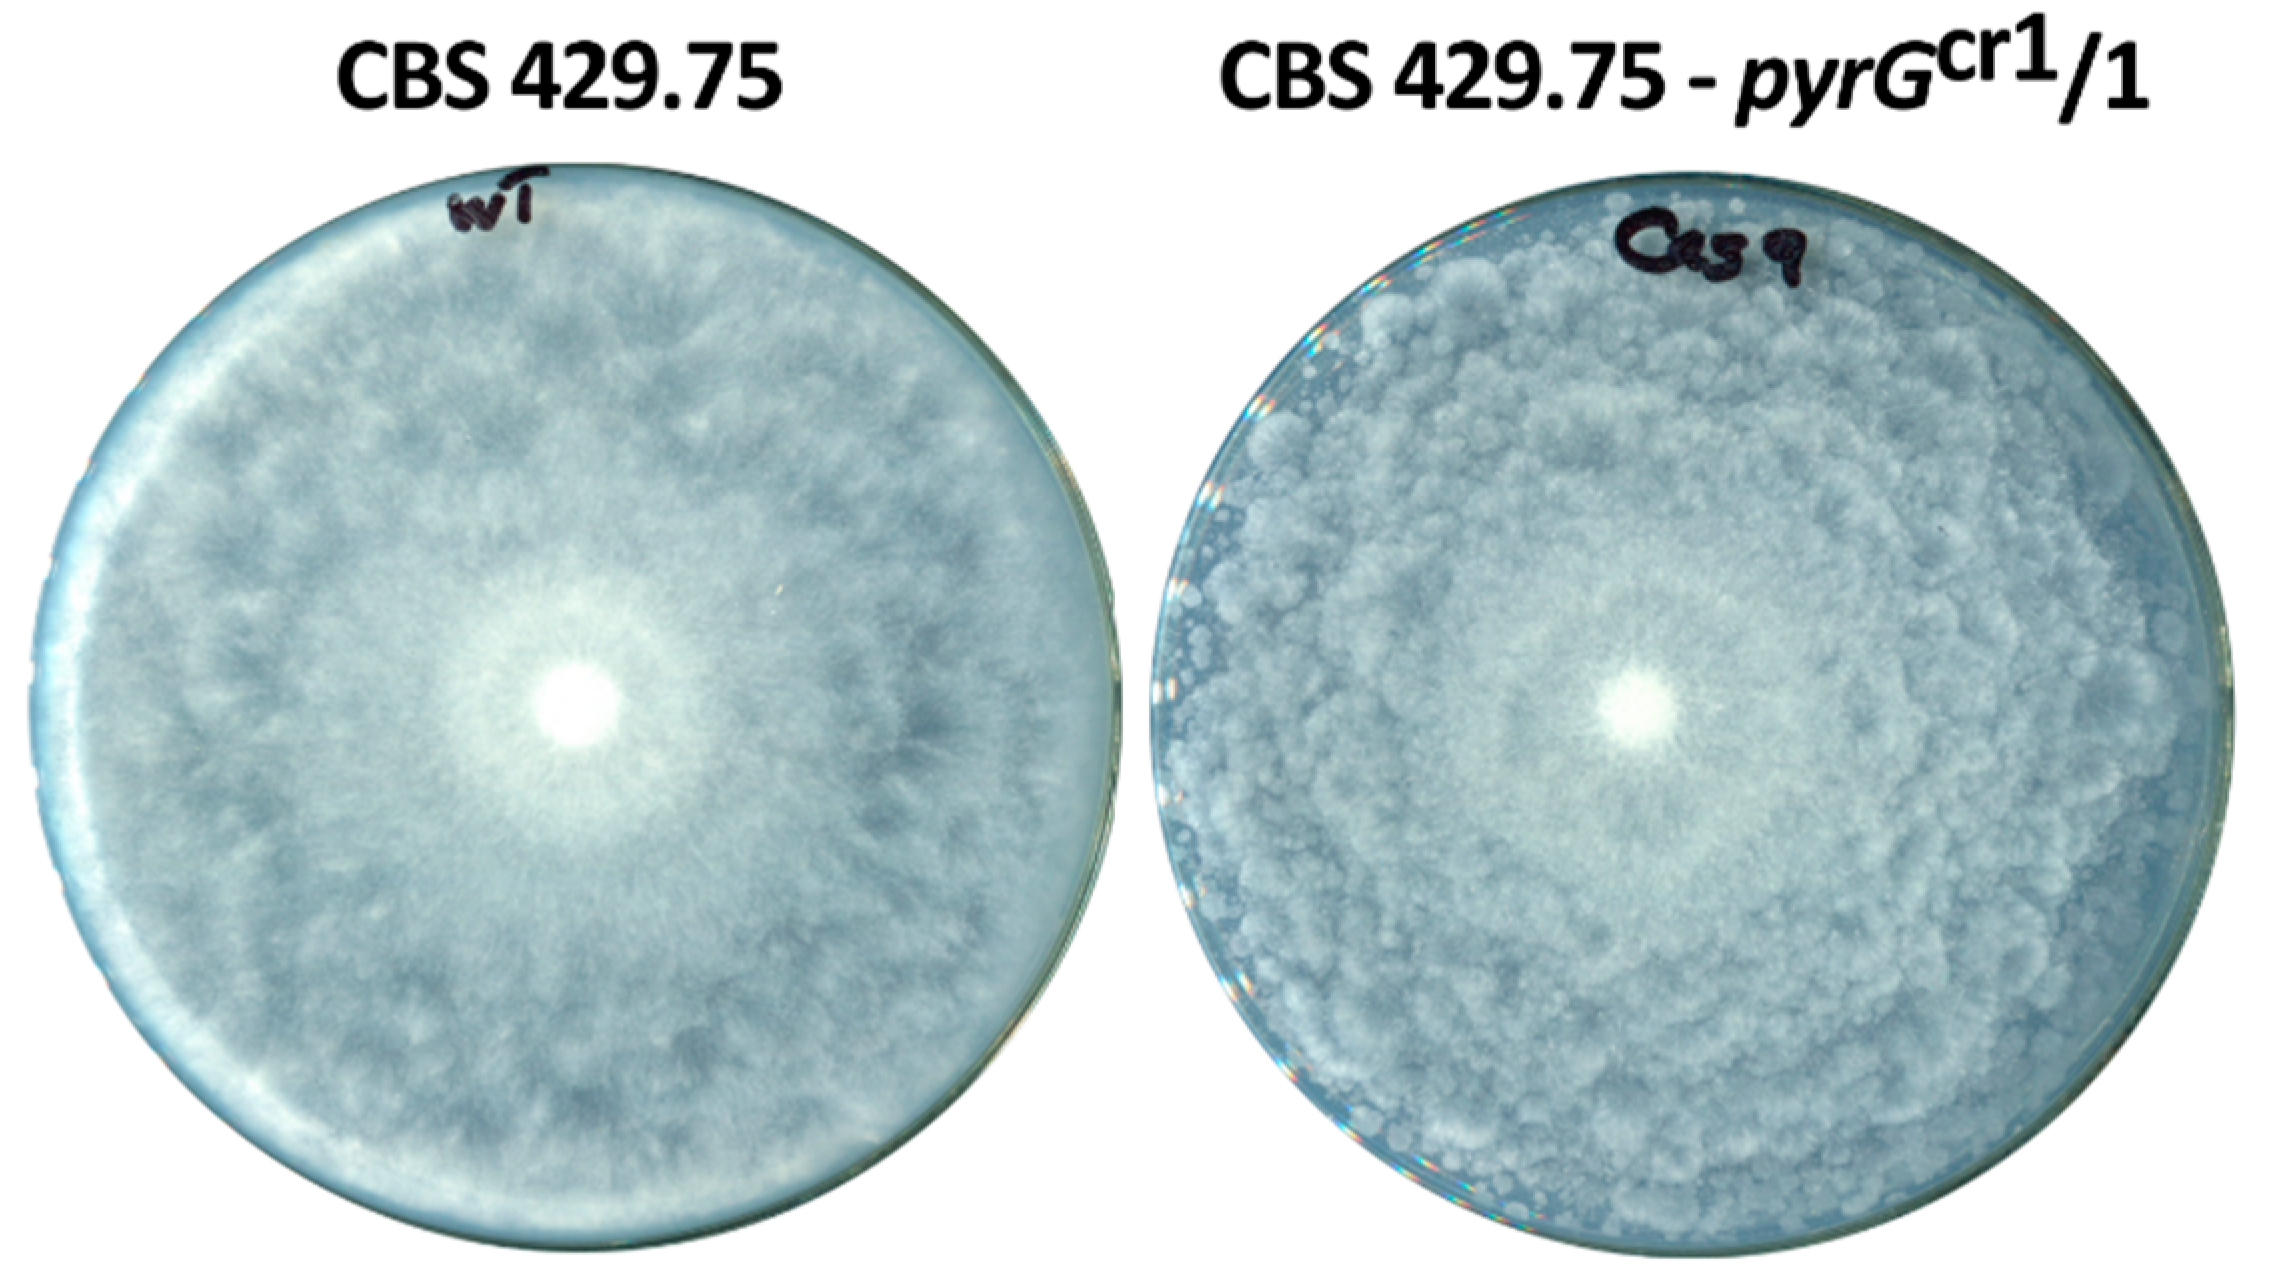
Ijms 21 03727 g004

CRISPR-Cas9-Based Mutagenesis of the Mucormycosis-Causing Fungus Lichtheimia corymbifera
Abstract
1. Introduction
2. Results
2.1. Disruption of the pyrG Gene in L. corymbifera
2.2. Evidence for CRISPR-Cas9-Mediated Disruption of the pyrG Gene
2.3. Characterization of the Disruption Mutants
3. Discussion
4. Materials and Methods
4.1. Strains, Media and Growth Conditions
4.2. Molecular Techniques and Design of the gRNA
4.3. Transformation
4.4. H2O2 Susceptibility Tests
4.5. Effect of Cell Wall Stressors
4.6. Survival Experiments in Drosophila melanogaster
4.7. Construction of Plasmids for the Complementation of Uracil Auxotrophy
4.8. Statistical Analyses
5. Conclusions
Author Contributions
Funding
Acknowledgments
Conflicts of Interest
Abbreviations
| 5-FOA | 5-fluoroorotic acid |
| Cas9 | CRISPR-associated protein 9 |
| CFW | calcofluor white |
| CRISPR | clustered regularly interspaced short palindromic repeats |
| crRNA | CRISPR-RNA |
| gRNA | guide RNA |
| H2O2 | hydrogen peroxide |
| HDR | Homology-directed repair |
| MEA | malt extract agar |
| NHEJ | non-homologous end-joining |
| OMP | orotidine 5′-phosphate |
| PAM | protospacer adjacent motif |
| PBS | phosphate buffer saline |
| PEG | polyethylene glycol |
| pyrF | orotate phosphoribosyl transferase gene |
| pyrG | orotidine 5′-phosphate decarboxylase gene |
| SDS | sodium dodecyl sulfate |
| tracrRNA | trans-activating crRNA |
| YNB | yeast nitrogen base |
References
- Riley, T.T.; Muzny, C.A.; Swiatlo, E.; Legendre, D.P. Breaking the mold: A review of mucormycosis and current pharmacological treatment options. Ann. Pharmacother. 2016, 50, 747–757. [Google Scholar] [CrossRef]
- Lanternier, F.; Dannaoui, E.; Morizot, G.; Elie, C.; Garcia-Hermoso, D.; Huerre, M.; Bitar, D.; Dromer, F.; Lortholary, O.; French Mycosis Study Group. A global analysis of mucormycosis in France: The RetroZygo Study (2005–2007). Clin. Infect. Dis. 2012, 54, S35–S43. [Google Scholar] [CrossRef]
- Garcia, A.; Vellanki, S.; Lee, S.C. Genetic tools for investigating Mucorales fungal pathogenesis. Curr. Clin. Microbiol. Rep. 2018, 5, 173–180. [Google Scholar] [CrossRef]
- Jeong, W.; Keighley, C.; Wolfe, R.; Lee, W.L.; Slavin, M.A.; Kong, D.C.M.; Chen, S.A. The epidemiology and clinical manifestations of mucormycosis: A systematic review and meta-analysis of case reports. Clin. Microbiol. Infect. 2019, 25, 26–34. [Google Scholar] [CrossRef]
- Gomes, M.Z.; Lewis, R.E.; Kontoyiannis, D.P. Mucormycosis caused by unusual mucormycetes, non-Rhizopus, -Mucor, and -Lichtheimia species. Clin. Microbiol. Rev. 2011, 24, 411–445. [Google Scholar] [CrossRef]
- Skiada, A.; Lanternier, F.; Groll, A.H.; Pagano, L.; Zimmerli, S.; Herbrecht, R.; Lortholary, O.; Petrikkos, G.L. Diagnosis and treatment of mucormycosis in patients with hematological malignancies: Guidelines from the 3rd European Conference on Infections in Leukemia (ECIL 3). Haematologica 2013, 98, 492–504. [Google Scholar] [CrossRef] [PubMed]
- Petrikkos, G.; Skiada, A.; Lortholary, O.; Roilides, E.; Walsh, T.J.; Kontoyiannis, D.P. Epidemiology and clinical manifestations of mucormycosis. Clin. Infect. Dis. 2012, 54, S23–S34. [Google Scholar] [CrossRef] [PubMed]
- Pana, Z.D.; Seidel, D.; Skiada, A.; Groll, A.H.; Petrikkos, G.; Cornely, O.A.; Roilides, E. Invasive mucormycosis in children: An epidemiologic study in European and non-European countries based on two registries. BMC Infect. Dis. 2016, 16, 667. [Google Scholar] [CrossRef] [PubMed]
- Walther, G.; Wagner, L.; Kurzai, O. Updates on the taxonomy of Mucorales with an emphasis on clinically important taxa. J. Fungi 2019, 5, 106. [Google Scholar] [CrossRef] [PubMed]
- Bitar, D.; Van Cauteren, D.; Lanternier, F.; Dannaoui, E.; Che, D.; Dromer, F.; Desenclos, J.-C.; Lortholary, O. Increasing incidence of zygomycosis (mucormycosis), France, 1997–2006. Emerg. Infect. Dis. 2009, 15, 1395–1401. [Google Scholar] [CrossRef]
- Bruni, G.O.; Zhong, K.; Lee, S.C.; Wang, P. CRISPR-Cas9 induces point mutation in the mucormycosis fungus Rhizopus delemar. Fungal Genet. Biol. 2019, 124, 1–7. [Google Scholar] [CrossRef] [PubMed]
- Ibrahim, A.S.; Skory, C.D. Genetic manipulation of Zygomycetes. In Medical Mycology: Cellular and Molecular Techniques; Kavanagh, K., Ed.; John Wiley & Sons: Hoboken, NJ, USA, 2007; pp. 305–326. [Google Scholar]
- Papp, T.; Csernetics, Á.; Nyilasi, I.; Ábrók, M.; Vágvölgyi, C. Genetic transformation of Zygomycetes fungi. In Progress in Mycology; Rai, M.K., Kövics, G.J., Eds.; Springer: Dordrecht, The Netherlands, 2010; pp. 75–94. [Google Scholar]
- Nagy, G.; Szebenyi, C.; Csernetics, Á.; Vaz, A.G.; Tóth, E.J.; Vágvölgyi, C.; Papp, T. Development of a plasmid free CRISPR-Cas9 system for the genetic modification of Mucor circinelloides. Sci. Rep. 2017, 7, 16800. [Google Scholar] [CrossRef] [PubMed]
- Nagy, G.; Vaz, A.G.; Szebenyi, C.; Takó, M.; Tóth, E.J.; Csernetics, Á.; Bencsik, O.; Szekeres, A.; Homa, M.; Ayaydind, F.; et al. CRISPR-Cas9-mediated disruption of the HMG-CoA reductase genes of Mucor circinelloides and subcellular localization of the encoded enzymes. Fungal Genet. Biol. 2019, 129, 30–39. [Google Scholar] [CrossRef] [PubMed]
- Boeke, J.D.; Trueheart, J.; Natsoulis, G.; Fink, G.R. 5-Fluoroorotic acid as a selective agent in yeast molecular genetics. Methods Enzymol. 1987, 154, 164–175. [Google Scholar]
- Liu, R.; Chen, L.; Jiang, Y.; Zhou, Z.; Zou, G. Efficient genome editing in filamentous fungus Trichoderma reesei using the CRISPR/Cas9 system. Cell Discov. 2015, 1, 10507. [Google Scholar] [CrossRef]
- Fuller, K.K.; Chen, S.; Loros, J.J.; Dunlap, J.C. Development of the CRISPR/Cas9 system for targeted gene disruption in Aspergillus fumigatus. Eukaryot. Cell 2015, 14, 1073–1080. [Google Scholar] [CrossRef]
- Min, K.; Ichikawa, Y.; Woolford, C.A.; Mitchell, A.P. Candida albicans gene deletion with transient CRISPR-Cas9 system. mSphere 2016, 1, e00130-16. [Google Scholar] [CrossRef]
- Enkler, L.; Richer, D.; Marchand, A.L.; Ferrandon, D.; Jossinet, F. Genome engineering in the yeast pathogen Candida glabrata using the CRISPR-Cas9 system. Sci. Rep. 2016, 6, 35766. [Google Scholar] [CrossRef]
- Arras, S.D.; Chua, S.M.; Wizrah, M.S.; Faint, J.A.; Yap, A.S.; Fraser, J.A. Targeted genome editing via CRISPR in the pathogen Cryptococcus neoformans. PLoS ONE 2016, 11, e0164322. [Google Scholar] [CrossRef]
- Shi, T.Q.; Liu, G.N.; Ji, R.Y.; Shi, K.; Song, P.; Ren, L.J.; Huang, H.; Ji, X.J. CRISPR/Cas9-based genome editing of the filamentous fungi: The state of the art. Appl. Microbiol. Biotechnol. 2017, 101, 7435–7443. [Google Scholar] [CrossRef]
- Kim, S.; Kim, D.; Cho, S.W.; Kim, J.; Kim, J.S. Highly efficient RNA-guided genome editing in human cells via delivery of purified Cas9 ribonucleoproteins. Genome Res. 2014, 24, 1012–1019. [Google Scholar] [CrossRef] [PubMed]
- Pohl, C.; Kiel, J.A.K.W.; Driessen, A.J.M.; Bovenberg, R.A.L.; Nygård, Y. CRISPR/Cas9 based genome editing of Penicillium chrysogenum. ACS Synth. Biol. 2016, 5, 754–764. [Google Scholar] [CrossRef] [PubMed]
- Nødvig, C.S.; Nielsen, J.B.; Kogle, M.E.; Mortensen, U.H. A CRISPR-Cas9 system for genetic engineering of filamentous fungi. PLoS ONE 2015, 10, e0133085. [Google Scholar] [CrossRef] [PubMed]
- D’Enfert, C.; Diaquin, M.; Delit, A.; Wuscher, N.; Debeaupuis, J.P.; Huerre, M.; Latge, J.P. Attenuated virulence of uridine-uracil auxotrophs of Aspergillus fumigatus. Infect. Immun. 1996, 64, 4401–4405. [Google Scholar] [CrossRef] [PubMed]
- Retallack, D.M.; Heinecke, E.L.; Gibbons, R.; Deepe, G.S.; Woods, J.P. The URA5 gene is necessary for Histoplasma capsulatum growth during infection of mouse and human cells. Infect. Immun. 1999, 67, 624–629. [Google Scholar] [CrossRef]
- Corbacho, I.; Teixidó, F.; Velázquez, R.; Hernández, L.M.; Olivero, I. Standard YPD, even supplemented with extra nutrients, does not always compensate growth defects of Saccharomyces cerevisiae auxotrophic strains. Antonie van Leeuwenhoek 2011, 99, 591–600. [Google Scholar] [CrossRef]
- Ying, S.H.; Feng, M.G.; Keyhani, N.O. Use of uridine auxotrophy (ura3) for markerless transformation of the mycoinsecticide Beauveria bassiana. Appl. Microbiol. Biotechnol. 2013, 97, 3017–3025. [Google Scholar] [CrossRef]
- Binder, U.; Navarro-Mendoza, M.I.; Naschberger, V.; Bauer, I.; Nicolas, F.E.; Pallua, J.D.; Lass-Flörl, C.; Garre, V. Generation of a Mucor circinelloides reporter strain—A promising new tool to study antifungal drug efficacy and mucormycosis. Genes 2018, 9, 613. [Google Scholar] [CrossRef]
- Swinnen, S.; Goovaerts, A.; Schaerlaekens, K.; Dumortier, F.; Verdyck, P.; Souvereyns, K.; van Zeebroeck, G.; Foulquié-Moreno, M.R.; Thevelein, J.M. Auxotrophic mutations reduce tolerance of Saccharomyces cerevisiae to very high levels of ethanol stress. Eukaryot. Cell 2015, 14, 884–897. [Google Scholar] [CrossRef]
- Folmer, V.; Pedroso, N.; Matias, A.C.; Lopes, S.C.; Antunes, F.; Cyrne, L.; Marinho, H.S. H2O2 induces rapid biophysical and permeability changes in the plasma membrane of Saccharomyces cerevisiae. Biochim. Biophys. Acta Biomembr. 2008, 1778, 1141–1147. [Google Scholar] [CrossRef]
- Schwartze, V.U.; Winter, S.; Shelest, E.; Marcet-Houben, M.; Horn, F.; Wehner, S.; Linde, J.; Valiante, V.; Sammeth, M.; Riege, K.; et al. Gene expansion shapes genome architecture in the human pathogen Lichtheimia corymbifera: An evolutionary genomics analysis in the ancient terrestrial mucorales (Mucoromycotina). PLoS Genet. 2014, 10, e1004496. [Google Scholar] [CrossRef] [PubMed]

| Designation | Sequence (5′–3′) | Position in the pyrG Gene |
|---|---|---|
| LcpyrGcr1 | acacgactttatgatattcg | 315–334 1 |
| LcpyrGcr2 | aatgaacgaacacgacgatg | 687–707 |
© 2020 by the authors. Licensee MDPI, Basel, Switzerland. This article is an open access article distributed under the terms and conditions of the Creative Commons Attribution (CC BY) license (http://creativecommons.org/licenses/by/4.0/).
Share and Cite
Ibragimova, S.; Szebenyi, C.; Sinka, R.; Alzyoud, E.I.; Homa, M.; Vágvölgyi, C.; Nagy, G.; Papp, T. CRISPR-Cas9-Based Mutagenesis of the Mucormycosis-Causing Fungus Lichtheimia corymbifera. Int. J. Mol. Sci. 2020, 21, 3727. https://doi.org/10.3390/ijms21103727
Ibragimova S, Szebenyi C, Sinka R, Alzyoud EI, Homa M, Vágvölgyi C, Nagy G, Papp T. CRISPR-Cas9-Based Mutagenesis of the Mucormycosis-Causing Fungus Lichtheimia corymbifera. International Journal of Molecular Sciences. 2020; 21(10):3727. https://doi.org/10.3390/ijms21103727
Chicago/Turabian StyleIbragimova, Sandugash, Csilla Szebenyi, Rita Sinka, Elham I. Alzyoud, Mónika Homa, Csaba Vágvölgyi, Gábor Nagy, and Tamás Papp. 2020. "CRISPR-Cas9-Based Mutagenesis of the Mucormycosis-Causing Fungus Lichtheimia corymbifera" International Journal of Molecular Sciences 21, no. 10: 3727. https://doi.org/10.3390/ijms21103727
APA StyleIbragimova, S., Szebenyi, C., Sinka, R., Alzyoud, E. I., Homa, M., Vágvölgyi, C., Nagy, G., & Papp, T. (2020). CRISPR-Cas9-Based Mutagenesis of the Mucormycosis-Causing Fungus Lichtheimia corymbifera. International Journal of Molecular Sciences, 21(10), 3727. https://doi.org/10.3390/ijms21103727

